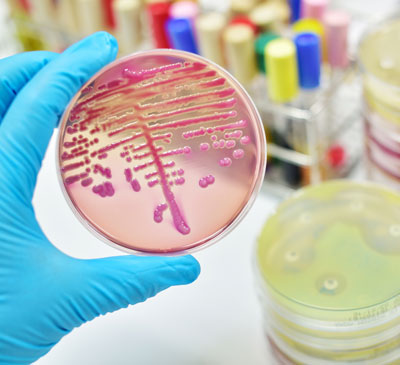
Global Industrial Microbiology Market 2018-2022

Below are some of the key findings from the industrial microbiology market research report:

See the complete table of contents and list of exhibits, as well as selected illustrations and example pages from this report.
Get a FREE sample now!
Global industrial microbiology industry overview
Microorganisms are increasingly being used for the production of various commercial products such as food, beverages, microbial enzymes, food additives, and supplements. Various activities are performed to produce commercial products from microorganisms which include isolation of microorganisms from nature, their screening for product formation, maintenance of cultures, mass culture using bioreactors, and retrieval of products, followed by their purification. All these activities require industrial microbiology products such as instruments and consumables, thereby increasing their demand. The increasing commercial use of microorganisms for production processes will fuel the industrial microbiology market growth during the forecast period.
The increasing prominence of promotional activities will be one of the key industrial microbiology market trends that will impact market growth during the forecast period. The restriction on the advertising and marketing of industrial microbiology products is resulting in a significant lack of awareness about such products. Several vendors are promoting the use of industrial microbiology products through websites. For instance, Thermo Fisher Scientific provides support material such as the explanation of techniques through brochures and PDF documents and interactive videos on YouTube to help end-users.
Top industrial microbiology companies covered in this market research report
The industrial microbiology market is fairly fragmented. By offering a complete analysis of the market’s competitive landscape and with information on the products offered by the companies, this industrial microbiology industry analysis report will aid clients identify new growth opportunities and design new growth strategies.
The report offers a complete analysis of various companies including:
- BD
- Bio-Rad Laboratories
- Eppendorf
- Merck KGaA
- QIAGEN
- Thermo Fisher Scientific
Industrial microbiology market segmentation based on geographic regions
- Americas
- APAC
- EMEA
With a complete study of the growth opportunities for the companies, the Americas will account for the highest industrial microbiology market share throughout the forecast period. Although the APAC region will hold the smallest share of the market, it will register the highest incremental growth during the forecast period.
Industrial microbiology market segmentation based on end-user
- Pharmaceutical industry
- Food and beverage industry
- Others
The pharmaceutical industry segment will account for the largest share on the industrial microbiology market. Additionally, the report also provides an accurate prediction of the contribution of the various segments to the growth of the industrial microbiology market size.
Key highlights of the global industrial microbiology market for the forecast years 2018-2022:
- CAGR of the market during the forecast period 2018-2022
- Detailed information on factors that will accelerate the growth of the industrial microbiology market during the next five years
- Precise estimation of the global industrial microbiology market size and its contribution to the parent market
- Accurate predictions on upcoming trends and changes in consumer behavior
- Growth of the industrial microbiology industry across the Americas, APAC, and EMEA
- A thorough analysis of the market’s competitive landscape and detailed information on several vendors
- Comprehensive details on the factors that will challenge the growth of industrial microbiology companies
We can help! Our analysts can customize this market research report to meet your requirements. Get in touch
RIA -
RIA - 
